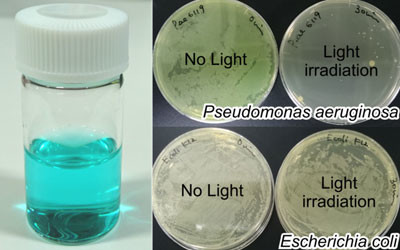
&#39;Trojan horse&#39; approach to antibiotic-resistant bacteria

'Trojan horse' approach to antibiotic-resistant bacteria
Japanese researchers have found that a deadly, antibiotic-resistant bacterium can be sterilised by hijacking its haem acquisition system, which is essential for its survival. Their work has been published in the journal ACS Chemical Biology.
Pseudomonas aeruginosa is a dangerous bacterium that causes infections in hospital settings and in people with weakened immune systems. It can cause blood infections and pneumonia, while severe infections can be deadly.
Highly resistant to antibiotic treatment, P. aeruginosa is one of the most critical pathogens urgently requiring alternative treatment strategies, according to the World Health Organization. It is also one of many bacteria that have evolved a system that allows them to acquire difficult-to-access iron from the human body.
Iron is essential for bacterial growth and survival, but in humans, most of it is held up within the ‘haem’ complex of haemoglobin. To get hold of it, P. aeruginosa and other bacteria secrete a protein, called HasA, which latches onto haem in the blood. This complex is recognised by a membrane receptor on the bacterium called HasR, permitting haem entry into the bacterial cell, while HasA is recycled to pick up more haem.
Bioinorganic chemist Osami Shoji, based at Nagoya University, collaborated with colleagues to hijack this ‘haem acquisition system’ for drug delivery. They developed a powder formed of HasA and the pigment gallium phthalocyanine (GaPc), which, when applied to a culture of P. aeruginosa, was consumed by the bacteria.
“When the pigment is exposed to near-infrared light, harmful reactive oxygen species are generated inside the bacterial cells,” Shoji said.
When tested, over 99.99% of the bacteria were killed following treatment with one micromolar of HasA with GaPc and 10 min of irradiation. The strategy also worked on other bacteria with the HasR receptor on their membranes, but not on ones without it.
The haem acquisition system is so essential to these bacteria’s survival that it is not expected to change, making it unlikely the bacteria will develop resistance to this drug strategy. The study authors wrote, “Our findings support the use of artificial haem proteins as a Trojan horse to selectively deliver antimicrobials to target bacteria, enabling their specific and effective sterilization, irrespective of antibiotic resistance.”
The researchers next aim to test their strategy for treating infections, and are working on modifying their approach for sterilising other pathogens that possess a similar haem acquisition system.
Please follow us and share on Twitter and Facebook. You can also subscribe for FREE to our weekly newsletters and bimonthly magazine.
AusBiotech partners with Tenmile
Designed to support Australia's homegrown life sciences innovation, AusBiotech has announced...
Australian CDC issues update in wake of Ebola outbreak
After the WHO determined the outbreak of Ebola in the DRC and Uganda to be a public health...
Australia announces $7.2m diphtheria outbreak response package
To respond to the biggest diphtheria outbreak on record, support has been announced for the NT...



